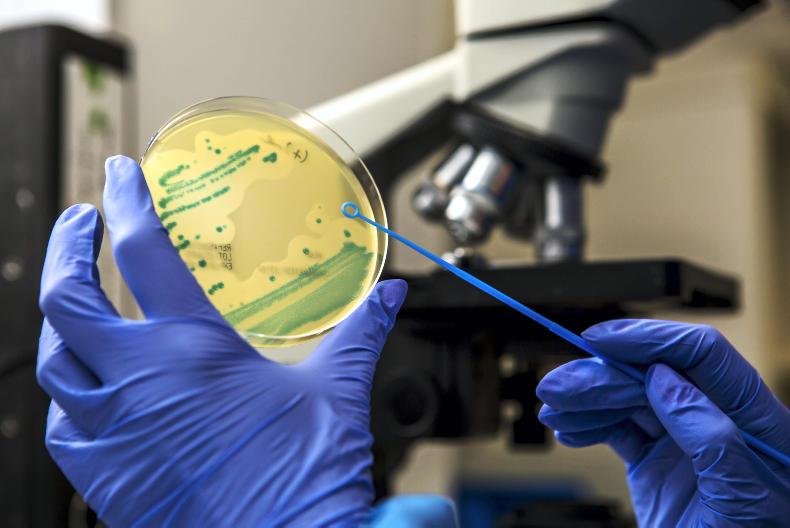
Cost saving causes disease surveillance revamp Cost saving causes disease surveillance revamp

Budget pressures for Scotland’s Rural College (SRUC) has meant it is implementing a new model for animal disease surveillance which will see the closure of the Ayr and Perth laboratories with new vet hubs used as a replacement. The changes implement the recommendations of the Kinnaird review for farm animal disease surveillance which includes consulting on the future of 35 jobs across the country. SRUC states that the changes were made against a “backdrop of pressure on budgets and the need for SRUC to find operational efficiencies”.
There is to be increased collaboration with veterinarian practitioners across the country, along with a new £1.6m SRUC Veterinary and Analytical Laboratory based inside the Moredun Research Institute on the Bush Estate, near Edinburgh.
Post-mortem examinations ceased in the Lothians and Inverness earlier this year, the post-mortem facilities in Ayr and Perth would close by 1 April 2020. The new veterinary hubs would operate locally to cover all four locations.
The post-mortem facilities in Aberdeen, Dumfries and St Boswells would remain in the new model. The post-mortem service in Thurso, which is managed in partnership with a local vet practice, would continue as well.
George Caldow, head of SRUC Veterinary Services, said: “The challenge has been to create a new model of disease surveillance that provides the necessary amount of coverage within a reduced budget. This led us to look at how we use technology and new approaches to improve efficiency and proactively look at improving animal production. This model will allow the expertise available within SRUC to be harnessed more effectively for the benefit of all livestock production in Scotland.
“The proposed new model has meant some difficult decisions about the closure of post-mortem facilities. Dairy, beef, sheep and pig surveillance will be supported by at least one post-mortem facility in an area of intensive production. The provision of post-mortem and pathology services will remain an essential part of our surveillance delivery model.
NFU Scotland president Andrew McCornick said: “This announcement will no doubt be a disappointment to our members as well as the local communities most impacted by potential closures and loss of high-quality jobs. Disease surveillance is a critical service for the livestock industry, and it is vital that it is not weakened through this rationalisation.
Centralisation
“Cost savings are necessary and there is logic in the centralisation of the diagnostic services and the increase in efficiency it provides as a result of the great advancements in technology which will allow for better and faster delivery of results from expert centres. Collaboration and centralised data collection are essential for effective disease surveillance.
“The proposal to maintain local presence through veterinary ‘hubs’ in the areas facing closure is encouraging. The working of these hubs and proposed greater practical involvement of local vets, carrying out sampling and on-farm post mortems, will be critical in how well the future service can deliver for both surveillance and farmer service.
“Greater collaboration and involvement of practising vets has potential to greatly add to the surveillance landscape and strengthen the relationship between farmers and local vets.”

SHARING OPTIONS